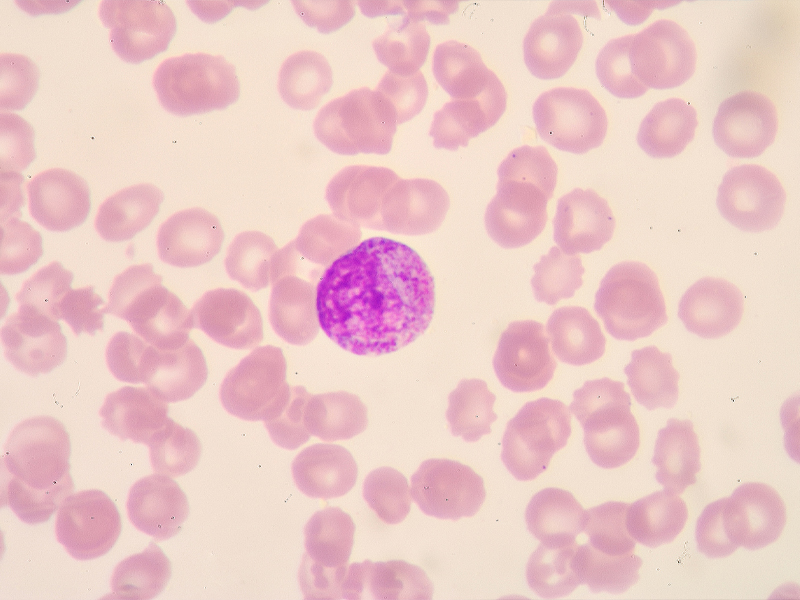
cell

Adherent cell culture is a fundamental technique widely used in cell biology, biotechnology, and biomedical research. However, due to the sensitivity of cells to environmental and operational conditions, various issues may arise during routine culture. Understanding the root causes and applying targeted solutions are essential to ensure stable cell growth and reliable experimental results.

01 Cells Fail to Attach
Possible Causes:
Over-trypsinization leading to cell damage
Mycoplasma contamination or cellular senescence
Alkaline culture medium (CO₂ imbalance or NaHCO₃ degradation)
Improper seeding density
Solutions:
Reduce trypsinization time or concentration
Test for contamination and discard affected cultures if necessary
Adjust CO₂ levels or correct medium pH
Optimize seeding density and use low-passage cells
02 Cell Clumping in Suspension
Possible Causes:
Presence of Ca²⁺/Mg²⁺ in medium
DNA release from lysed cells
Over-digestion or contamination
Solutions:
Wash cells with Ca²⁺/Mg²⁺-free buffer
Gently pipette to obtain single-cell suspension
Apply DNase treatment if needed
Eliminate contamination sources
03 Slow Cell Growth
Possible Causes:
Sudden change of medium or serum
Depletion of key nutrients (e.g., glutamine, growth factors)
Hidden contamination (bacteria, fungi, mycoplasma)
Low seeding density or aging cells
Solutions:
Gradually adapt cells to new culture conditions
Use fresh medium or supplement essential nutrients
Maintain strict aseptic technique
Increase seeding density and refresh cell stocks
04 Poor Cell Condition
Key Factors:
Cell status: high passage number, improper digestion, low viability
Contamination: mycoplasma or fungal infection
Culture system: unsuitable or unvalidated medium/serum
Environment: unstable temperature or CO₂ supply
Optimization Tips:
Control passage number and maintain cell vitality
Use validated reagents and culture systems
Strengthen contamination control practices
Ensure stable incubator performance
05 Cell Death
Possible Causes:
CO₂ depletion or temperature fluctuation
Damage during freezing/thawing
Incorrect osmolarity or toxic metabolite accumulation
Solutions:
Regularly monitor incubator conditions
Standardize cryopreservation and recovery procedures
Replace with fresh culture medium
Use healthy, well-preserved cell stocks

Labant Insight:
Consistent cell culture performance relies on three core elements: healthy cells, standardized procedures, and a controlled environment. By implementing good laboratory practices and routine monitoring, most common culture issues can be effectively prevented.
Follow on WeChat
Copyright @ 2024 Shanghai Welso Technology Co.,Ltd.